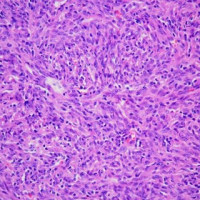
磷钨酸苏木.精染色

万千商家帮你免费找货
0 人在求购买到急需产品
- 详细信息
- 询价记录
- 技术资料
- 服务名称:
病理常规HE染色实验服务
- 提供商:
晶莱生物
- 规格:
切片
一、染色目的
病理学的所有切片,都必须通过一种以上的染料,通过各种不同的方法,将切片中各种不同的物质,在不同染液的作用下,将其显示出来,使之在光学显微镜下,能够完全的观看各种结构。例如,HE染色,好质量的切片可以清晰地显示出许多不同的结构,细胞核着蓝黑色,细胞浆着粉红色,软骨着蓝色等。清晰的结构为诊断提供可靠的依据,因此,染色技术也是病理技术中的重要组成部分,必须不断地总结,方能提高。如果染色不好,切片染色一团糟,红蓝不分,结构不清,层次不明,影响了镜下的观察,直接影响了临床诊断,染色结果的好坏直接关系到诊断的准确性。
二、染色方法及步骤
1.人工苏木素,伊红染色法(HE法)
(1)切片浸入二甲苯中5-10min;
(2)切片浸入二甲苯中5-10min;
(3)100%酒精1min。
(4)100%酒精1min。
(5)95%酒精1min。
(6)95%酒精1min。
(7)90%酒精1min。
(8)80%酒精1min。
(9)自来水洗1min。
(10)浸入苏木素染液浸染10-15min。
(11)自来水洗30second-1min。
(12)1%盐酸酒精分化30second。
(13)流水冲洗15min以上。
(14)1%伊红酒精染3-5min。
(15)90%或95%酒精分化30sec。
(16)95%酒精30sec-1min。
(17)95%酒精30sec-1min。
(18)95%酒精30sec-1min。
(19)100%酒精1min。
(20)100%酒精1-2min。
(21)碳酸二甲苯1min。
(22)二甲苯1-2min。
(23)二甲苯1-2min
(24)二甲苯1-2min。
(25)中性树胶封固。结果:细胞核被染成深蓝黑色;细胞浆被染成粉红色;软骨及钙盐被染成蓝色;胶原纤维染成淡粉红色,嗜酸性细胞及嗜酸性颗粒呈鲜红色;弹力纤维呈淡粉红色;某些蛋白性物呈粉红色等。
样片参考:

肠

鼻粘膜

肺

肝

肌肉横截面

脑

胃

心脏

子宫

细胞
晶莱生物病理类实验服务总览表
| 类别 | 服务项目 | 备注 | 说明 |
| 制 片 前 处 理 |
石蜡包埋 | 包埋1块 | 固定后组织按客户要求取材,脱水,包埋成蜡块(进口石蜡) |
| 特殊包埋(细胞、材料、眼球等) | 包埋1块 | 包埋要求难度较高(含特殊位置取材) | |
| 石蜡组织芯片 | 阵列点位包埋 | 客户提供供体蜡块及标本信息 | |
| 软化(肝硬化、皮肤结痂、植物等) | 1块标本软化 | 较为坚硬组织软化处理 | |
| 骨组织脱钙(小) | 1块标本脱钙 | 最大面≤2cm²骨组织脱钙 | |
| 骨组织脱钙(大) | 1块标本脱钙 | 最大面>2cm²骨组织脱钙 | |
| 骨组织EDTA脱钙(小) | 1块标本脱钙 | 最大面≤2cm²骨组织EDTA脱钙 | |
| 骨组织EDTA脱钙(大) | 1块标本脱钙 | 最大面>2cm²骨组织EDTA脱钙 | |
| 石蜡白片 | 石蜡白片1片 | 组织防脱载玻片石蜡白片 | |
| 冰冻组织制备 | 冰冻包埋及前处理 | 4%多.聚.甲.醛固定的组织或OCT包裹的新鲜组织(-80℃或液氮内保存,干冰运输) | |
| 冰冻切片 | 冰冻组织切片1片 | 同一组织连续切片3张以上免制备费 | |
| 染 色 |
HE染色 | 染色含切片 | 苏木.精-伊红染色法,观察组织形态 |
| 油红O染色 | 染色含冰冻切片 | 4%多.聚.甲.醛固定,冰冻切片。对组织内脂质(如脂滴)染色 | |
| 番红O固绿染色 | 染色含切片 | 常用于植物、软骨组织形态染色 | |
| Masson染色 | 染色含切片 | 观察组织纤维化和肌纤维的鉴别及组织纤维化程度 | |
| 天狼猩红染色 | 染色含切片 | 观察组织纤维化程度,及偏振光进行胶原亚型的分区 | |
| PAS糖原染色 | 染色含切片 | 观察肝脏、肌肉等组织内糖原的变化;肠胃肺支气管等杯状细胞酸性粘液物质变化 | |
| 阿利新蓝染色 | 染色含切片 | 常用于软骨组织或早幼粒细胞、巨核细胞染色 | |
| 甲苯.胺蓝染色 | 染色含切片 | 观察软骨组织形态或组织内肥大细胞的数量及分布 | |
| 尼氏染色 | 染色含切片 | 观察脑或脊髓等中枢神经系统内神经元尼氏体的变化 | |
| LFB髓鞘染色 | 染色含切片 | 观察神经髓鞘的形态及变化 | |
| 普鲁士蓝染色 | 染色含切片 | 常用于吞噬细胞内铁粒子的含量和定位 | |
| VG染色 | 染色含切片 | 显示组织胶原纤维及肌纤维的形态及变化 | |
| EVG染色 | 染色含切片 | 观察血管弹性纤维的形态及变化 | |
| VonKossa染色 | 染色含切片 | 观察组织内病理性钙沉积情况 | |
| 刚果红染色 | 染色含切片 | 一般用于组织淀粉样变染色 | |
| 维多利亚蓝染色 | 染色含切片 | 用于弹力纤维染色 | |
| 免疫 组化 |
免疫组化预式 | 染色含切片 | 试两个一抗浓度后拍照 |
| 免疫组化正式 | 染色含切片 | 客户提供一抗,常用二抗公司提供 | |
| 免疫组化芯片 | 染色含切片 | 免疫组化组织芯片染色 | |
| 免疫荧光(石蜡-单标) | 染色含切片和拍照 | 需实验前商定拍照倍数及视野 | |
| 免疫荧光(石蜡-双标) | 染色含切片和拍照 | 需实验前商定拍照倍数及视野 | |
| 免疫荧光(冰冻-单标) | 染色含冰冻切片和拍照 | 需实验前商定拍照倍数及视野 | |
| 免疫荧光(冰冻-双标) | 染色含冰冻切片和拍照 | 需实验前商定拍照倍数及视野 | |
| 抗体代购 | 详情请咨询工作人员 | ||
| Tunel | Tunel(POD自带试剂盒) | 染色含切片 | 细胞凋亡染色,客户需提供Tunel试剂盒 |
| Tunel(公司提供试剂盒) | 细胞凋亡染色,公司提供罗氏POD Tunel试剂盒 | ||
| 凋亡试剂盒代购 | 染色含切片 | 详情请咨询工作人员 |
晶莱病理实验室:长沙实验室;北京实验室;提前预约免费上门取样!
更多病理学实验服务内容详情请咨询晶莱生物!
晶莱生物服务流程

收费标准/服务周期/提供结果:
欢迎咨询详谈,我们会根据您的方案及需求制定详细的服务协议。
更多实验技术服务请浏览网站其他内容,或来电咨询!
做实验,找晶莱!您的科研生涯,我们一路相伴!
【平台项目开展范围】慢病毒,腺病毒,RNAi类,分子生物实验,病理实验,免疫学实验,细胞实验,动物实验,蛋白组学实验,芯片类实验,并为广大客户朋友们提供课题设计指导、基金申请指导等服务。
【北京公司】北京经济技术开发区科创十三街12号院德为科技园1号楼5层
【长沙公司】长沙市高新区麓谷大道627号新长海中心A1-1203室
【晶莱生物】已开展了数千个实验外包项目。我们专注于医学课题研究,已从课题申请、方案设计、试剂采购、模型构造、标本检测、数据分析,各个环节积累了数千个成功案例经验,为数千个来自临床的科研工作者解决了大量的科研问题。更多相关实验服务信息请咨询晶莱生物
风险提示:丁香通仅作为第三方平台,为商家信息发布提供平台空间。用户咨询产品时请注意保护个人信息及财产安全,合理判断,谨慎选购商品,商家和用户对交易行为负责。对于医疗器械类产品,请先查证核实企业经营资质和医疗器械产品注册证情况。
- 作者
- 内容
- 询问日期
技术资料暂无技术资料 索取技术资料